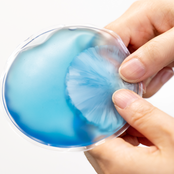
リサイクルエコカイロ

秋・冬の一覧
7 件中 1~7件までを表示
-
No.0015828
ノルディニット 湯たんぽ⇒単価217.8円
(税抜単価:198円)【上代】900円
印刷なし64個ご注文時 -
No.0015827
アニマルメリー フェイスブランケット⇒単価173.8円
(税抜単価:158円)【上代】700円
印刷なし64個ご注文時 -
No.0015826
スクエアUSBエコカイロ⇒単価982.3円
(税抜単価:893円)【上代】1,880円
印刷なし100個ご注文時 -
- フルカラーOK
No.0015825
コンパクトUSB加湿器⇒単価227.7円
(税抜単価:207円)【上代】495円
印刷なし120個ご注文時
-
- アソート販売
No.0015812
デイタス ラージブランケット⇒単価173.8円
(税抜単価:158円)【上代】700円
印刷なし240枚ご注文時 -
- 説明会向け
No.0015607
リサイクルエコカイロ⇒単価125.4円
(税抜単価:114円)【上代】245円
印刷なし120個ご注文時 -
- SDGs
No.0015593
ベルト付エコブランケット⇒単価238.7円
(税抜単価:217円)【上代】495円
印刷なし100個ご注文時
- 1
7 件中 1~7件までを表示